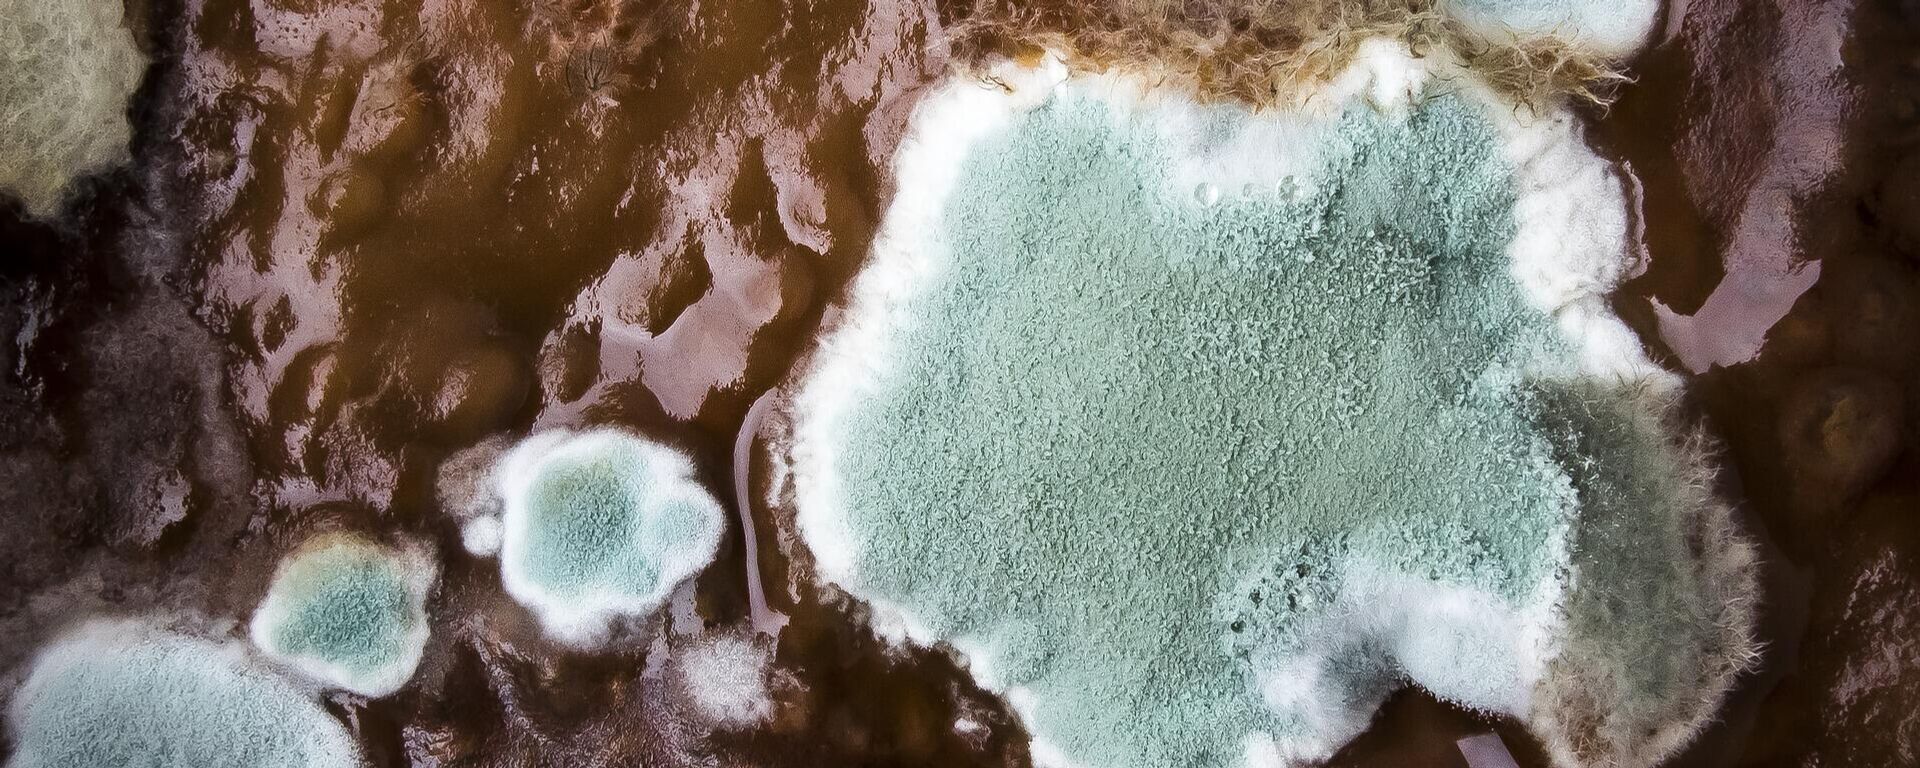
Moho en alimentos - Sputnik Mundo, 1920, 12.08.2021

https://noticiaslatam.lat/20211025/cuatro-usos-de-los-hongos-que-seguramente-no-conocias-1117489637.html
Cuatro usos de los hongos que seguramente no conocías
Cuatro usos de los hongos que seguramente no conocías
Sputnik Mundo
Los hongos tienen propiedades naturales que han sido vitales para varias industrias, lo que los ha convertido en un factor importante para la economía mundial... 25.10.2021, Sputnik Mundo
2021-10-25T17:49+0000
2021-10-25T17:49+0000
2021-10-25T17:49+0000
estilo de vida
comida
naturaleza
alimentos saludables
🥚 alimentación
biología
hongos
https://cdn.img.noticiaslatam.lat/img/07e5/0a/19/1117490327_0:0:1280:721_1920x0_80_0_0_2c202e36f61c09319e61fbe362d1b421.jpg
Se calcula que en el mundo existen más de 10 millones de especies de hongos, los cuales son considerados uno de los grupos de organismos más grandes en cuanto a número de individuos y variedad, ocupando el segundo lugar después de los insectos.Por su extensa variedad, los hongos se han utilizado en diversos procesos industriales para la obtención de numerosos productos, lo que ha sido vital para la economía mundial, señala Celia Elvira Aguirre Acosta, académica del Instituto de Biología (IB) y encargada de la Colección de Hongos del Herbario Nacional de México de la UNAM. Te presentamos cuatro usos de los hongos que seguramente no conocías. Elvira Aguirre Acosta detalló que estos organismos tienen un papel importante en el reciclaje de la materia orgánica, al ser descomponedores por excelencia porque producen una gran cantidad de enzimas con las cuales pueden degradar infinidad de sustratos.
https://noticiaslatam.lat/20210812/el-moho-en-los-alimentos-que-tan-peligroso-es-1115029732.html
https://noticiaslatam.lat/20211021/siete-beneficios-para-tu-salud-que-puedes-obtener-al-consumir-yogurt--1117351424.html
Sputnik Mundo
contacto@sputniknews.com
+74956456601
MIA „Rossiya Segodnya“
2021
Sputnik Mundo
contacto@sputniknews.com
+74956456601
MIA „Rossiya Segodnya“
Noticias
es_ES
Sputnik Mundo
contacto@sputniknews.com
+74956456601
MIA „Rossiya Segodnya“
https://cdn.img.noticiaslatam.lat/img/07e5/0a/19/1117490327_143:0:1280:853_1920x0_80_0_0_eac1a467a82e41ba741033cc6ad71e32.jpgSputnik Mundo
contacto@sputniknews.com
+74956456601
MIA „Rossiya Segodnya“
comida, naturaleza, alimentos saludables, 🥚 alimentación, biología, hongos
comida, naturaleza, alimentos saludables, 🥚 alimentación, biología, hongos
Cuatro usos de los hongos que seguramente no conocías
Los hongos tienen propiedades naturales que han sido vitales para varias industrias, lo que los ha convertido en un factor importante para la economía mundial, de acuerdo con una experta de la Universidad Nacional Autónoma de México (UNAM).
Se calcula que en el mundo existen más de 10 millones de especies de
hongos, los cuales son considerados uno de los grupos de organismos más grandes en cuanto a número de individuos y variedad, ocupando el segundo lugar después de los insectos.
Por su extensa variedad, los hongos se han utilizado en diversos procesos industriales para la obtención de numerosos productos, lo que ha sido vital para la economía mundial,
señala Celia Elvira Aguirre Acosta, académica del Instituto de Biología (IB) y encargada de la Colección de Hongos del Herbario Nacional de México de la UNAM.
12 de agosto 2021, 21:12 GMT
Te presentamos cuatro usos de los hongos que seguramente no conocías.
1.
Se utiliza para la maduración de quesos como el roquefort y el camembert.
2.
Los hongos también son utilizados en la obtención de la penicilina, una de las medicinas más importantes a nivel mundial que es utilizada para el combate de las bacterias causantes de numerosas enfermedades de vías respiratorias causadas por patógenos bacterianos como los estreptococos, de las vías urinarias, de la piel, del oído, del estómago e incluso de los huesos.
3.
A partir de los hongos también se obtienen enzimas para la elaboración de textiles, papel y pieles.
4.
En México los hongos tienen, además de un valor culinario, cultural, pues algunos hongos contienen compuestos químicos con propiedades medicinales; mientras que también existen algunas especies tóxicas, algunas de ellas letales o alucinógenas, cuyo consumo data de épocas prehispánicas.
Elvira Aguirre Acosta detalló que estos organismos tienen un papel importante en el reciclaje de la materia orgánica, al ser descomponedores por excelencia porque producen una gran cantidad de
enzimas con las cuales pueden degradar infinidad de sustratos.

21 de octubre 2021, 13:04 GMT